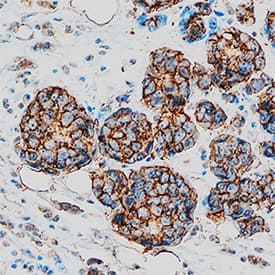
AG-2/AGR2 antibody in Human Breast Cancer Tissue by Immunohistochemistry (IHC-P).

Human AG-2/AGR2 Antibody
R&D Systems, part of Bio-Techne | Catalog # AF6068


Key Product Details
Species Reactivity
Validated:
Cited:
Applications
Validated:
Cited:
Label
Antibody Source
Product Specifications
Immunogen
Arg21-Leu175
Accession # O95994
Specificity
Clonality
Host
Isotype
Scientific Data Images for Human AG-2/AGR2 Antibody
Detection of Human AG-2/AGR2 by Western Blot.
Western blot shows lysates of A549 human lung carcinoma cell line and human small intestine tissue. PVDF Membrane was probed with 1 µg/mL of Sheep Anti-Human AG-2/AGR2 Antigen Affinity-purified Polyclonal Antibody (Catalog # AF6068) followed by HRP-conjugated Anti-Sheep IgG Secondary Antibody (Catalog # HAF016). A specific band was detected for AG-2/AGR2 at approximately 20 kDa (as indicated). This experiment was conducted under reducing conditions and using Immunoblot Buffer Group 8.AG-2/AGR2 in Human Breast Cancer Tissue.
AG-2/AGR2 was detected in immersion fixed paraffin-embedded sections of human breast cancer tissue using Sheep Anti-Human AG-2/AGR2 Antigen Affinity-purified Polyclonal Antibody (Catalog # AF6068) at 10 µg/mL overnight at 4 °C. Tissue was stained using the Anti-Sheep HRP-DAB Cell & Tissue Staining Kit (brown; Catalog # CTS019) and counterstained with hematoxylin (blue). Specific staining was localized to plasma membrane in cancer cells. View our protocol for Chromogenic IHC Staining of Paraffin-embedded Tissue Sections.Applications for Human AG-2/AGR2 Antibody
Immunohistochemistry
Sample: Immersion fixed paraffin-embedded sections of human breast cancer tissue
Western Blot
Sample: A549 human lung carcinoma cell line and human small intestine tissue
Formulation, Preparation, and Storage
Purification
Reconstitution
Formulation
Shipping
Stability & Storage
- 12 months from date of receipt, -20 to -70 °C as supplied.
- 1 month, 2 to 8 °C under sterile conditions after reconstitution.
- 6 months, -20 to -70 °C under sterile conditions after reconstitution.
Background: AG-2/AGR2
AG-2 (Anterior gradient protein 2; also AGR2, GOB4 and HPC8) is an 18‑21 kDa member of the PDI family of enzymes. It is expressed in secretory cell types, such as prostate epithelium, small intestine goblet, Paneth and enteroendocrine cells, and multiple carcinoma cell types. Although AG-2 possesses a signal sequence, it appears to be rarely secreted, instead being found in the ER due the presence of a KTEL ER retention signal at its C-terminus. AG-2 forms transient disulfide linkages with molecules destined for secretion, possibly aiding protein folding. Mature human AG-2 is 155 amino acids (aa) in length (aa 21‑175). Cys81 is presumed to participate in intermolecular bond formation. There is one potential alternative start site 20 aa upstream of the standard start site. Over aa 21‑175, human AG-2 shares 94% aa identity with mouse AG-2.
Long Name
Alternate Names
Gene Symbol
UniProt
Additional AG-2/AGR2 Products
Product Documents for Human AG-2/AGR2 Antibody
Product Specific Notices for Human AG-2/AGR2 Antibody
For research use only